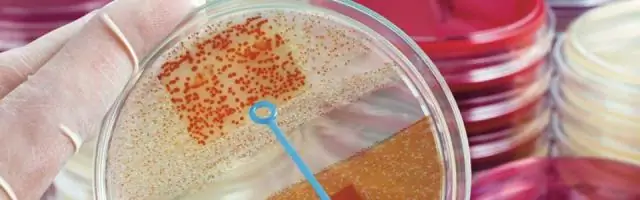
Бактерии с множественной лекарственной устойчивостью от кур представляют опасность для здоровья человека

Изоляты распространенного патогена домашней птицы, собранные у животных на птичьих рынках в Индии, были в основном устойчивы к нескольким классам антибиотиков. В исследовании представлены первые данные о распространенности и выделении Helicobacter pullorum в Индии. Исследование опубликовано 4 ноября в Applied and Environmental Microbiology, журнале Американского общества микробиологии.
В ходе исследования исследователи секвенировали геномы 11 изолятов патогена H. pullorum от цыплят-бройлеров и цыплят свободного выгула с рынков в Хайдарабаде, Индия. Каждый из них содержал пять или шесть хорошо охарактеризованных генов устойчивости к противомикробным препаратам. Изоляты были устойчивы к фторхинолонам, цефалоспоринам, сульфаниламидам, макролидам и другим антибиотикам. Кроме того, они продуцировали бета-лактамазы расширенного спектра действия, ферменты, которые делали их устойчивыми к антибиотикам пенициллинового семейства.
Скрининг вирулентности выявил 182 важных гена вирулентности в изолятах.
Соавтор Нияз Ахмед, доктор философии, профессор биотехнологии и биоинформатики Университета Хайдарабада, Индия, сказал, что H. pullorum потенциально может быть патогенным для домашней птицы и человека, и объяснил, что сообщалось о случаях кишечных заболеваний человека, вызванных этой бактерией. Он также сказал, что он несет токсин, который может нарушать клеточный цикл и вызывать повреждение ДНК, что может привести к раку.
Х. pullorum может стать проблемой общественного здравоохранения, сказал Ахмед, из-за способности вызывать рак, а также из-за того, что «в таких странах, как Индия, H. pullorum от домашней птицы может быть полирезистентным уже из-за преобладающих методов животноводства».
Отсутствие исследований распространенности H. pullorum в Индии послужило толчком для исследования, сказал Ахмед. «Для отбора проб мы нацелились на птицефабрики на влажных рынках, помня о том, что домашнюю птицу в Индии часто кормят антибиотиками, чтобы способствовать увеличению веса. Такая практика, скорее всего, способствует распространению устойчивых к лекарствам патогенов среди животных и людей, что представляет значительный риск для здоровья населения.."
«Наше исследование предполагает, что куры могут быть основным источником передачи появляющегося возбудителя МЛУ, H. pullorum, от домашней птицы к человеку», - заключили исследователи. Кроме того, они написали, что исследование убедительно подтверждает гипотезу о том, что этот вид является новым патогеном, поскольку он тесно связан с установленными патогенами, такими как Campylobacter jejuni. Учитывая распространенность H. pullorum среди индийской курицы, как описано в исследовании, полмиллиарда индийцев, которые едят курицу, и тот факт, что потребление курицы растет на огромные 12 процентов в год, вероятность распространения множественной лекарственной устойчивости снижается. «тревожно», - написали исследователи.